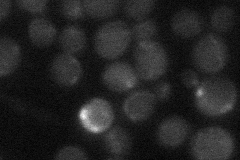
YPR005C

View description
Cytoplasmic protein involved in halotolerance; decreases intracellular Na+ (via Ena1p) and increases intracellular K+ by decreasing efflux; expression repressed by Ssn6p-Tup1p and Sko1p and induced by NaCl, KCl, and sorbitol through Gcn4p
Localization:
Intensity:
Fold change:
Significance:
-
C’ GFP library in SD

below threshold16.55 -
N' NOP1pr-GFP in SD

nucleus41.6214 -
N' TEF2pr-mCherry in SD

nucleus10.7481 -
N' NATIVEpr-GFP in SD
punctate19.8817 -
N' TEF2pr-VC and Cyto-VN in SD

below threshold25.8214 -
C’ GFP library in SD+DTT

cytosol20.51.23No -
C’ GFP library in SD+H2O2

cytosol16.460.99No -
C’ GFP library in Starvation Media

cytosol19.951.2No -
C’ GFP library on the background of Pup2-DaMP

below threshold -
C’ GFP library on the background of CCT mutant

below threshold18.17531.09748No
